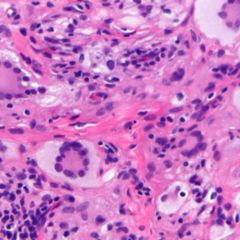
Xanthogranulom DocCheck Flexikon

Ein Juveniles Xanthogranulom (JXG) ist eine im Säuglings- und Kleinkindesalter auftretende gutartige Form einer Histiozytose.
Synonyme sind: Naevoxanthoendotheliom; Naevoxanthom; Xanthoma juvenile; juveniles Riesenzellgranulom; Xanthelasma naeviforme
Verbreitung
Es handelt sich um die häufigste Form einer juvenilen Nicht-Langerhans-Zell-Histiozytose. Gehäuft kommen Neurofibromatose Typ 1 oder eine juvenile Chronische myeloische Leukämie vor.
Ursache
Die Ursache ist bislang nicht geklärt.
Klinische Erscheinungen
Klinische Kriterien sind:
- Hautveränderungen in den ersten Lebensjahren, bis 20 % bereits bei Geburt.
- Meist Kopf und Stamm betroffen
- Meistens einzelne, gelegentlich multilokuläre oder disseminierte weiche, Papeln oder Knoten von 1–3 cm Größe, zunächst rot, dann gelblich.
Diagnose
Die Diagnose ergibt sich aus den klinischen Befunden.
Differentialdiagnose
Abzugrenzen sind Histiozytose X, eine Mastozytose, tuberöse Xanthome, Xanthelasmoide Form einer Urticaria pigmentosa, Diktyom.
Therapie und Prognose
Die Erkrankung bildet sich in der Regel im Laufe einiger Jahre von selbst zurück, wobei Hyperpigmentierungen verbleiben.
Geschichte
Die Bezeichnung wurde im Jahre 1954 durch E. B. Helwig und V. C. Hackney geprägt.
Die Erstbeschreibung durch N. F. Adamson stammt aus dem Jahre 1905.
Literatur
- M. S. Israel, R. Carlos, F. R. Pires: Oral Juvenile Xanthogranuloma: Report of Two Cases. In: Pediatric dentistry, Mai 2017, Band 39, Nr. 3, S. 238–240; PMID 28583250.
- C. Martínez-Morán, B. Echeverría-García, J. C. Tardío, J. Borbujo: Ultrasound Appearance of Juvenile Xanthogranuloma. In: Actas dermo-sifiliograficas. [elektronische Veröffentlichung vor dem Druck] März 2017; doi:10.1016/j.ad.2016.11.021, PMID 28372783.
- D. Raffin, C. Gardair-Bouchy, M. Samimi, P. Guadagnin, A. Maruani: Xanthogranulome juvénile chez une enfant de 4 ans. In: Archives de Pédiatrie: organe officiel de la Societe francaise de pediatrie, März 2017, Band 24, Nr. 3, S. 298–300; doi:10.1016/j.arcped.2016.11.022, PMID 28161231.
Weblinks
- emedicine.medscape
Einzelnachweise